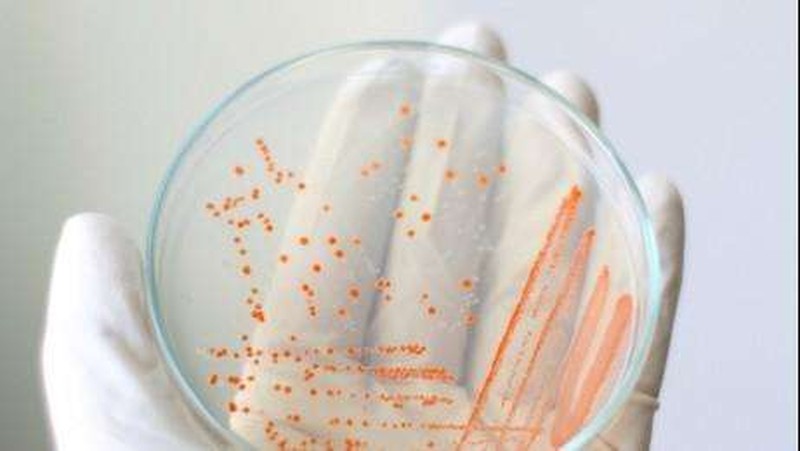
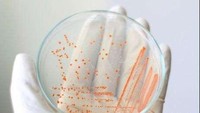
Yang pastinya gatal-gatal karena adanya banyak kuman dalam tubuh. Apalagi jika tidak mandi, tubuh akan lebih sering berkeringat dan menjadi tempat lembab yang asik untuk kuman berkembang biak.

Jangan Malas Mandi! Ini Efeknya yang Tidak Bisa Diabaikan

Mandi menggunakan air dingin bisa mengeluarkan ion-ion negatif dalam tubuh. Jika kita tidak mandi, otomatis tubuh akan mudah lelah dan tidak bersemangat sepanjang hari.